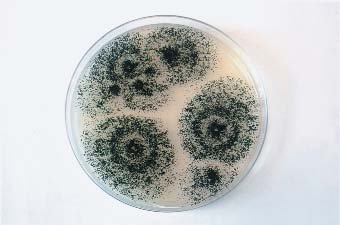

티스토리 뷰
목차
대설은 24절기 중 하나로, 눈이 많이 내린다는 뜻을 지닌 절기입니다. 양력으로 12월 7일경에 해당하며, 겨울이 본격적으로 시작되는 시기를 알립니다. 이 시기에는 북서풍이 강하게 불고 기온이 급격히 내려가면서 전국적으로 강설이 잦아집니다. 농촌에서는 대설을 앞두고 농사 마무리와 겨울철 준비를 서두르며, 한 해의 마지막 농작물 수확을 마칩니다. 대설은 겨울의 시작을 의미하는 동시에, 한 해의 마무리 준비를 알리는 중요한 절기라 할 수 있습니다.

24절기와 관련 정보 알아보기
| 24절기 개요 | 입춘 | 우수 |
| 경칩 | 춘분 | 청명 |
| 곡우 | 입하 | 소만 |
| 망종 | 하지 | 소서 |
| 대서 | 입추 | 처서 |
| 백로 | 추분 | 한로 |
| 상강 | 입동 | 소설 |
| 대설 | 동지 | 소한 |
| 대한 |
1. 대설(大雪) 요약
| 날짜(기간) | 12.7~8 (12월 1일~15일) |
| 계절특징 | 눈이 많이 온다. |
| 농사일 | 농한기 |
| 전통음식 | 콩비지찌개, 두부음식 |
| 관련속담 | 겨울에 눈이 많이 오면 풍년든다. |
※ 대설의 한자 풀이
- 대(大): 클 "대" – "크다"는 뜻으로, 이 한자는 많은 양을 상징하며, 이 경우에는 "큰 눈"을 의미합니다.
- 설(雪): 눈 "설" – "눈"을 의미하는 한자로, 하늘에서 내리는 눈을 뜻합니다.
따라서 대설(大雪)이라는 한자는 "큰 눈"을 의미하며, 겨울철 중 눈이 많이 내리는 시기를 뜻합니다. 이는 24절기 중에서도 눈이 많이 내리는 때라는 점을 강조하여 표현한 것입니다.
2. 대설 절기와 주요 기단의 관계
대설(大雪)은 "큰 눈이 내린다"는 의미로, 본격적인 겨울이 시작되는 시기입니다. 양력으로 12월 7~8일 무렵에 해당하며, 이때부터 겨울의 기운이 본격적으로 나타나고 차가운 날씨가 자리를 잡습니다. 대설과 관련된 주요 기단의 관계는 다음과 같습니다.
○ 시베리아 기단의 강한 영향: 시베리아 기단은 북쪽 시베리아 지역에서 발생하는 차갑고 건조한 대륙성 한대 기단입니다. 대설 무렵부터 이 기단은 강력한 한파와 건조한 날씨를 불러일으킵니다. 대륙성 기단의 특성상 맑고 차가운 날씨가 이어지며, 때때로 강풍이 동반되기도 합니다. 대설 시기에는 시베리아 기단이 남하하여 한반도를 완전히 덮으며 기온이 급격히 떨어지고 겨울철의 본격적인 추위가 시작됩니다. 대설 이후에는 기온이 더욱 낮아지면서 전국적으로 겨울철의 맹추위가 본격화됩니다. 시베리아 기단의 영향을 받으면서 차갑고 건조한 날씨가 이어지고, 낮과 밤의 기온 차이가 커지며 맑고 차가운 날씨가 지속됩니다. 특히 한파와 더불어 대륙성 고기압에 의해 삼한사온 현상이 시작되어 3일간 강추위가 지속되고 4일간 온화한 날씨가 반복되는 패턴이 나타나기도 합니다.
○ 오호츠크해 기단의 영향 약화: 오호츠크해 기단은 차갑고 습한 해양성 한대 기단으로, 늦봄부터 초여름에 주로 영향을 미치던 기단입니다. 이 기단은 대설 무렵에는 세력이 약해져 거의 소멸 상태에 이르며, 겨울철 기온과 강수량에 영향을 미치지 않습니다. 대설 시기에는 오호츠크해 기단의 영향이 거의 없으므로 차갑고 건조한 시베리아 기단이 기후의 대부분을 차지하게 됩니다. 오호츠크해 기단의 잔재로 인해 일부 지역에서는 간헐적인 눈이 내릴 수 있지만, 이는 점차 소멸하여 주로 맑고 차가운 날씨가 지속됩니다. 오호츠크해 기단의 잔재가 남아 있더라도, 시베리아 기단의 세력이 강해 눈이 내리는 지역이 일부 있을 수 있습니다. 이로 인해 대설을 기점으로 전국적으로 추운 겨울 날씨가 본격화되며 눈이 내리는 경우도 늘어납니다.
○ 북태평양 기단의 완전 소멸: 북태평양 기단은 여름철 덥고 습한 날씨를 형성하는 해양성 열대 기단으로, 여름과 초가을까지 한반도에 영향을 주던 기단입니다. 대설 무렵에는 북태평양 기단의 영향이 완전히 사라져 겨울철 기단에 영향을 미치지 않습니다. 여름철 무더위를 일으키던 북태평양 기단은 가을 초반에 이미 후퇴했으며, 대설 시기에는 완전히 소멸해 추위가 강해지는 시베리아 기단의 영향을 받게 됩니다. 북태평양 기단이 완전히 사라지면서 남아 있던 온난한 기운이 없어지고, 대설 이후의 날씨는 오직 시베리아 기단의 차갑고 건조한 기운에 의해 겨울철 기온이 낮게 유지됩니다.
대설 시기에는 시베리아 기단의 차갑고 건조한 기운이 완전히 자리 잡으면서 강력한 한파와 함께 본격적인 겨울이 시작됩니다. 오호츠크해 기단은 거의 영향력이 사라지며, 북태평양 기단은 완전히 소멸한 상태로 한반도는 시베리아 기단의 영향권에 들어갑니다. 이로 인해 전국적으로 기온이 떨어지고 눈이 내리는 현상이 늘어나는 등 한반도 전역에 겨울철 날씨가 뚜렷하게 나타나게 됩니다.
| 계절 | 봄 | 여름 |
| 절기 | 입춘, 우수, 경칩, 춘분, 청명, 곡우 | 입하, 소만, 망종, 하지, 소서, 대서 |
| 주요 기단 | 양쯔강 기단, 시베리아 기단 | 북태평양 기단, 오호츠크해 기단 |
| 날씨 특성 | 건조하고 따뜻한 날씨, 꽃샘추위, 황사 | 덥고 습한 날씨, 장마, 불볕더위, 열대야 |
| 계절 | 가을 | 겨울 |
| 주요 절기 | 입추, 처서, 백로, 추분, 한로, 상강 | 입동, 소설, 대설, 동지, 소한, 대한 |
| 주요 기단 | 양쯔강 기단, 북태평양 기단 | 시베리아 기단 |
| 날씨 특성 | 맑고 건조한 날씨, 큰 일교차 | 춥고 건조한 날씨, 삼한사온 |
3. 동양과 서양의 계절 구분 🍂❄️
동양과 서양의 계절 구분 방식은 지역적 기후 조건과 전통적 생활 방식에 따라 고유하게 발전했습니다.
동양에서는 24절기를 바탕으로 계절을 나누며, 이는 중국에서 기원해 한국, 일본, 베트남 등지로 전파된 전통적인 시간 체계입니다. 1년을 24개의 절기로 세분화하여 자연의 미묘한 변화를 반영하며 농사와 생활에 맞춘 대응을 가능하게 했습니다. 동양의 겨울은 입동(立冬)부터 대한(大寒)까지 포함되며, 입동은 겨울의 시작을 알리고 서리와 함께 기온이 내려갑니다. 이어지는 소설(小雪)은 첫눈이 내릴 가능성을 나타내며, 대설(大雪)은 눈이 가장 많이 내리는 시기입니다. 동지(冬至)에는 낮이 가장 짧고 밤이 길어지며, 이후로 햇빛이 강해지는 시기를 맞이합니다. 겨울의 끝에는 소한(小寒)과 대한이 있으며, 한 해 중 가장 추운 시기로서 겨울이 절정을 이룹니다. 이렇게 세분화된 절기는 농사와 가족 건강 관리에 중요한 역할을 했습니다.
서양에서는 천문학적 계절 구분을 따르며, 태양의 위치와 깊은 관련이 있습니다. 서양의 사계절 구분은 춘분(春分), 하지(夏至), 추분(秋分), 동지(冬至)와 같은 주요 천문학적 현상을 중심으로 이뤄집니다. 예를 들어, 서양에서 가을은 추분(9월 22일경)부터 시작되며 날씨가 서늘해지고, 동지를 기점으로 본격적인 겨울이 시작됩니다. 따라서, 서양은 추분 이후부터 동지 전까지를 가을로 보고, 동지 이후부터는 겨울로 인식합니다. 이 계절 구분 방식은 천문학적 현상을 기준으로 하며, 자연의 변화뿐만 아니라 크리스마스와 같은 축제 및 연중 행사를 통해 계절감을 느끼게 됩니다.
이처럼 동양에서는 농업과 생활에 맞춰 계절을 세분화해온 반면, 서양은 천문학적 기준으로 계절을 구분하여 자연과의 관계를 상징적으로 해석했습니다. 동양의 절기 구분은 농경 사회에서 농사 계획, 가족 건강 관리 등 일상에 밀접하게 사용되었고, 서양은 천문학적 기준으로 자연 현상에 초점을 맞추어 계절의 의미를 강조하는 경향이 있었습니다.
4. 대설과 농작물 보호 🌾
대설(大雪)은 24절기 중 하나로, 음력으로 11월경에 해당하며 눈이 많이 내리는 시기를 뜻합니다. 이 시기에는 본격적인 겨울이 시작되며, 기온이 급격히 낮아지면서 한반도 전역에서 눈이 자주 내립니다. 대설에 내리는 눈은 겨울철 농작물에 자연스럽게 이불 역할을 하여 보온을 제공합니다. 이러한 이유로 “눈은 보리의 이불이다”라는 속담이 전해져 내려오며, 이는 눈이 농작물 보호에 중요한 역할을 한다는 의미를 담고 있습니다.


겨울철 월동 작물로 심어지는 보리는 이 시기에 차가운 기온에 견뎌야 하기 때문에, 추위에 대한 보호가 필수적입니다. 보리가 자라는 동안 눈이 내리면 눈이 땅을 덮어 보온층을 형성하게 되며, 이렇게 덮인 눈이 땅속의 온도를 유지해 줍니다. 눈이 덮인 땅은 공기가 잘 통하지 않아 열이 빠져나가지 못하고 일정 온도가 유지되는데, 이로 인해 땅속 온도가 극도로 떨어지지 않게 됩니다. 만약 눈이 덮여 있지 않다면 차가운 바람과 극심한 한파가 작물에 직접 닿아 월동 작물이 얼어버릴 수 있습니다.
또한, 눈이 녹을 때 천천히 땅으로 스며들어 수분 공급 역할도 합니다. 겨울철 내내 눈이 녹아 땅에 천천히 스며들기 때문에 월동 작물이 자라는데 필요한 수분을 확보할 수 있습니다. 이는 봄이 되어 보리가 본격적으로 자라기 시작할 때 도움이 되며, 땅이 건조해지는 것을 막아줘 작물이 더 건강하게 성장할 수 있는 기반이 됩니다. 이러한 효과 덕분에 겨울에 충분한 눈이 내린 경우 봄에는 농작물이 보다 잘 자라 풍작을 기대할 수 있습니다.
따라서 “눈은 보리의 이불이다”라는 속담은 단순히 눈이 내리는 겨울 풍경을 묘사하는 것이 아니라, 대설의 눈이 보리와 같은 겨울 작물에게 보온과 수분을 공급해주어 자연적인 보호 역할을 한다는 의미를 담고 있습니다.
| 속담 | 의미 |
| 대설에 눈이 많이 오면 다음 해 풍년이 든다 | 대설에 내린 눈이 땅을 덮어 보온 역할을 하여 농작물의 피해를 막아주기 때문에 풍년이 예측된다는 의미 |
| 눈은 보리의 이불이다 | 겨울철에 내린 눈이 땅을 덮어주면, 보리와 같은 작물의 생육에 도움이 되어 보호 역할을 한다는 의미 |
| 대설의 눈은 곡식의 보약이다 | 대설에 내리는 눈은 땅의 온도를 유지해주고, 농작물이 자라기에 좋은 환경을 만든다는 뜻 |
| 대설에 눈이 오면 이듬해 장마가 많다 | 대설에 많은 눈이 오면 그 해 여름철 장마가 길어질 수 있다는 의미로, 겨울 강수량이 여름 기후에 영향을 미친다고 여겼음 |
| 대설에 눈이 없으면 내년 농사가 어렵다 | 대설에 눈이 내리지 않으면 땅이 얼어붙어 농사에 어려움이 예상된다는 뜻 |
5. 풍년을 예고하는 대설 ❄️
대설(大雪)은 24절기 중 하나로, 음력 11월경 눈이 가장 많이 내린다는 의미를 지니고 있습니다. 이 절기에는 본격적으로 겨울이 시작되며, 눈이 내리는 날이 잦아지고 기온이 큰 폭으로 떨어져 한 해의 농사가 마무리됩니다. 대설에 눈이 많이 내리면, 농부들은 다음 해에 풍년이 들고 겨울을 따뜻하게 보낼 수 있을 것이라는 기대를 가지게 됩니다. 이는 단순한 기후적 특성만이 아닌, 전통적 속설과 농촌의 오랜 경험에 기반한 지혜를 담고 있습니다.



1. 대설과 풍년의 연관성: 대설에 내리는 눈은 겨울 작물과 토양을 보호하는 데 중요한 역할을 합니다. 전통적인 속설에 따르면, 대설에 많은 눈이 내리면 그해 겨울 동안 땅이 충분히 보온되어 얼지 않게 되고, 이는 다음 해의 농작물 성장에 긍정적인 영향을 미친다고 여겨집니다. 특히 겨울 작물인 보리는 눈이 땅을 덮어줌으로써 추위와 서리에 덜 노출되며, 이러한 보온 효과 덕분에 겨울을 잘 견딜 수 있습니다. 이 때문에 "눈은 보리의 이불이다"라는 속담이 전해져 내려옵니다. 겨울 동안 내린 눈이 보리밭을 따뜻하게 덮어줌으로써 보리가 얼어붙는 것을 막고, 봄철에 건강하게 자랄 수 있는 바탕을 만들어준다는 의미입니다. 이는 겨울철 눈이 내리는 양에 따라 그해의 풍년과 농작물의 품질이 달라질 수 있다는 믿음과 연결됩니다.
2. 대설과 농한기의 시작: 대설은 농부들에게 한 해 농사의 마무리를 의미합니다. 이 시기까지 농작물의 수확이 끝나며, 겨울 동안 농사일을 잠시 쉬어가는 농한기가 시작됩니다. 대설은 그래서 농한기의 첫 절기이기도 합니다. 농한기는 농사가 주업이었던 전통 농촌 사회에서 매우 중요한 시기였습니다. 이 시기에는 다음 해 농사를 위한 준비와 가정의 살림살이를 정리하며, 장담그기, 메주 띄우기 등 집안일을 준비하는 때로도 활용되었습니다. 특히 '농가월령가'라는 조선 후기의 농민가요에서도 대설 시기를 맞아 농한기 동안 할 일들을 언급하고 있습니다. 이 시기에 담근 장은 온 가족의 겨울 양식을 책임질 뿐만 아니라, 다음 해까지 이어지는 저장식품의 기본이 되기 때문에 매우 중요했습니다.


3. 겨울철 전통 음식 준비: 대설을 지나며 농부들은 본격적으로 집안일과 장 담그기, 메주 띄우기 등 전통 음식 준비에 돌입하게 됩니다. 대설 즈음에는 메주를 띄워 발효시키는 일도 많았습니다. 겨울철의 메주는 적절한 기온과 습도에서 잘 발효되며, 이때 만든 된장과 간장은 여름 동안 숙성되어 다음 해의 장 맛을 좌우하게 됩니다. 메주를 만드는 과정은 콩을 푹 삶아 잘 으깬 뒤 동그랗게 또는 네모지게 모양을 만들어 말리며, 짚을 깔아 발효를 돕는 전통 방식을 따릅니다. 짚에 효소가 있어 메주의 발효를 촉진하고, 주된 미생물인 바실러스 서브틸리스(Bacillus subtilis)가 짚을 기반으로 잘 자라면서 메주가 발효됩니다. 이는 오랜 세월에 걸쳐 전해져 내려온 전통 방식으로, 농부들은 대설을 맞아 가족의 건강과 양식을 위한 메주를 정성껏 만들며 겨울을 준비했습니다. 메주 발효균은 주로 곰팡이류와 세균류로 구성되어 있으며, 발효 과정에서 중요한 역할을 합니다. 전통적으로 사용하는 발효균들은 다음과 같습니다.
○ 곰팡이류 (주로 Aspergillus 및 Rhizopus 속): 메주 발효에서 가장 중요한 곰팡이입니다. Aspergillus oryzae는 아미노산과 당을 생성해 메주가 짠맛과 단맛을 갖게 하고, 효소를 통해 단백질을 분해하여 된장, 간장 등의 발효를 돕습니다. Rhizopus는 메주의 질감과 향을 부드럽게 만드는 역할을 합니다.
○ 젖산균 (Lactobacillus 속): 젖산균은 발효 과정에서 유산을 생성하여 메주의 신맛을 더하고, 잡균을 억제하여 위생적으로 유지하게 돕습니다.
○ 효모류 (Saccharomyces 속): 발효 과정에서 알코올과 이산화탄소를 생성하여 특유의 향과 맛을 더합니다. 효모는 발효 기간 동안 메주의 풍미를 높이는 중요한 역할을 합니다.
이러한 미생물들이 메주의 발효에 관여하여 된장, 간장, 고추장과 같은 전통 장류의 독특한 맛과 향을 완성시킵니다.

4. 따뜻한 겨울을 기대하며: 대설에 눈이 많이 내리면 따뜻한 겨울을 보낼 수 있다는 속설도 있습니다. 겨울철 눈은 땅의 온도를 유지해주고 추위로부터 보호해 주는 역할을 합니다. 이는 전통적인 농경 사회에서 추운 겨울을 대비하고 풍년을 기원하는 상징적인 의미도 함께 내포하고 있습니다. 자연의 변화에 따라 작물을 보호하고, 풍년과 가족의 건강을 기원하며 한 해를 마무리하는 대설은 농부들에게는 의미가 깊은 절기입니다.


6. 농한기에 메주를 띄우는 전통 🌱
대설 즈음 농한기가 시작되면, 농촌에서는 각 가정마다 메주를 띄워 된장과 간장을 준비하는 전통이 이어졌습니다. 농한기는 농작업이 대부분 마무리된 뒤 겨울철 휴식기이자 다음 해를 준비하는 중요한 시기로, 이때 집집마다 담근 메주는 온 가족의 겨울 양식뿐만 아니라 다음 해까지 이어지는 중요한 저장식품이 되었습니다. 이러한 메주 만들기는 전통 가요 '농가월령가'에서도 언급될 만큼 중요한 가사 활동으로 여겨졌으며, 정성 들여 만들어진 메주는 장맛에 큰 영향을 미쳤습니다. 한국 전통 장류에서 된장과 간장은 요리의 기본이자 필수 양념으로 사용되기 때문에, 겨울철 메주 만들기는 가정의 건강과 음식의 맛을 좌우하는 중요한 일이었습니다.

메주 만드는 과정 🍲
메주는 단순한 발효식품이 아니며, 자연과 조화하는 전통적 방식에 따라 오랜 시간 동안 숙성되어 만들어집니다. 메주를 만드는 과정은 먼저 잘 씻은 콩을 고온에서 익혀 콩을 부드럽게 삶아내는 것으로 시작합니다. 삶아진 콩은 으깨어 한 덩어리로 만든 후, 동그랗거나 네모지게 모양을 잡아 말리는데, 이때 모양을 잡은 메주는 방에 두어 서서히 건조시킵니다. 건조한 후에는 짚을 깔아 발효 과정을 돕습니다. 짚에는 자연 효소가 있어 발효가 원활히 일어나도록 하는데, 이는 메주가 잘 띄워질 수 있는 전통 방식입니다.

메주 발효의 주요 미생물은 바실러스 서브틸리스(Bacillus subtilis)로, 이 미생물은 짚에서 서식하는 특성이 있어 짚을 깔고 메주를 띄우는 방식이 적합합니다. 바실러스 서브틸리스는 메주를 발효시키면서 된장과 간장의 독특한 맛과 향을 형성하는 데 중요한 역할을 합니다. 이 전통적인 발효 방식은 오랜 세월 동안 내려온 지혜로, 발효과학이 발달한 현대에도 여전히 자연 발효의 장점을 살린 방법으로 인정받고 있습니다.
7. 결론: 대설의 의미를 되새기며 ❄️
대설은 눈이 많이 내리는 절기로 겨울의 본격적인 시작을 알리는 동시에, 농작물 보호와 풍년을 기원하는 의미를 지니고 있습니다. 또한 농한기에 이루어지는 전통적인 메주 발효 과정은 자연과 조화롭게 살아가는 농촌의 지혜를 엿볼 수 있게 해줍니다.


